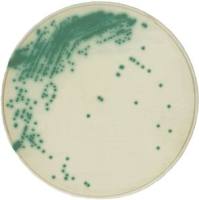
Chromagar-科马嘉

相关产品推荐更多 >
万千商家帮你免费找货
0 人在求购买到急需产品
- 详细信息
- 询价记录
- 技术资料
- 保质期:
12
- 库存:
100
- 供应商:
广州市益满生物科技有限公司
双胍类(降糖)快速筛查试剂盒说明书,双胍类(降糖)快速检测试剂盒
【用 途】 本试剂盒用于检验药品、保健品和食品,尤其是用于降糖类产品中是否添加
双胍类成分,适用于监管现场检验和实验室检验。
【规 格】 10次/盒。
【灵 敏 度】 0.08mg/ml。
【贮 藏】 常温,避光。
【包 装】 检测液A,检测试剂B,检测液C(红盖),5ml检测管10支,反应板10片,
毛细点样管10支,吸管1包。
【适用范围】 降糖类健康产品中的盐酸苯乙双胍、盐酸二甲双胍、盐酸丁双胍(丁二胍),
可检测胶囊剂、片剂、丸剂、散剂等固体剂型样品。不适用于软胶囊剂、液体制剂、单次用
量超过6g样品的快筛。
【使用方法】
显色剂的制备:
取1支检测试剂B加入检测液C至1ml刻度线处,放置10分钟以上,待溶液褪去红色(显黄色或黄绿色),方可使用。
样品处理:
【注意事项】
【用 途】 本试剂盒用于检验药品、保健品和食品,尤其是用于降糖类产品中是否添加
双胍类成分,适用于监管现场检验和实验室检验。
【规 格】 10次/盒。
【灵 敏 度】 0.08mg/ml。
【贮 藏】 常温,避光。
【包 装】 检测液A,检测试剂B,检测液C(红盖),5ml检测管10支,反应板10片,
毛细点样管10支,吸管1包。
【适用范围】 降糖类健康产品中的盐酸苯乙双胍、盐酸二甲双胍、盐酸丁双胍(丁二胍),
可检测胶囊剂、片剂、丸剂、散剂等固体剂型样品。不适用于软胶囊剂、液体制剂、单次用
量超过6g样品的快筛。
【使用方法】
显色剂的制备:
取1支检测试剂B加入检测液C至1ml刻度线处,放置10分钟以上,待溶液褪去红色(显黄色或黄绿色),方可使用。
样品处理:
- 按不同剂型取样加至检测管中:硬胶囊旋开胶囊壳,取约1粒内容物(如结块,应尽量压碎或剪碎);片剂、颗粒剂,压成粉末,取1片(颗)量;水丸加1.5ml。
- 向5ml检测管中加入3ml检测液A,盖上盖子,振摇30秒,静置30秒,待测。
- 用毛细管吸取待测液上清液(2-3秒),将毛细管对准反应板中心,垂直与反应板接触(2-3秒)。
- 待反应板上点样挥发干,用吸管吸取显色剂,对准点样位置滴加1滴试剂,观察显色板显色情况。
- 0分钟时,若不显色,或显淡黄色、淡棕色(见比色卡图1),不再观察,判为阴性(-)。
- 0分钟时,若显棕色、红色、紫色或深红色,可镊起反应板在吸水纸上吸去多余显色液,5分钟内继续观察:4-5分钟,呈红色、紫红色或深红色(见比色卡图2),判为阳性(+);5分钟内,颜色消失,或呈棕色、黄色、淡黄色,判为阴性(-)。
【注意事项】
- 本试剂盒仅供定性筛查用。
- 当气温较低,可用手握住试剂瓶或浸泡在20-40℃的温水中加热,加快显色液制备。
- 显色液久置后如变色或出现沉淀,请勿使用。
- 试剂具有腐蚀性,应小心操作,勿沾染皮肤,如误入眼中,请立即用大量清水冲洗。
- 试剂易挥发,每次操作完后,应拧紧瓶盖。
风险提示:丁香通仅作为第三方平台,为商家信息发布提供平台空间。用户咨询产品时请注意保护个人信息及财产安全,合理判断,谨慎选购商品,商家和用户对交易行为负责。对于医疗器械类产品,请先查证核实企业经营资质和医疗器械产品注册证情况。
- 作者
- 内容
- 询问日期
技术资料暂无技术资料 索取技术资料
双胍类(降糖)快速筛查试剂盒说明书,双胍类(降糖)快速检测试剂盒
询价